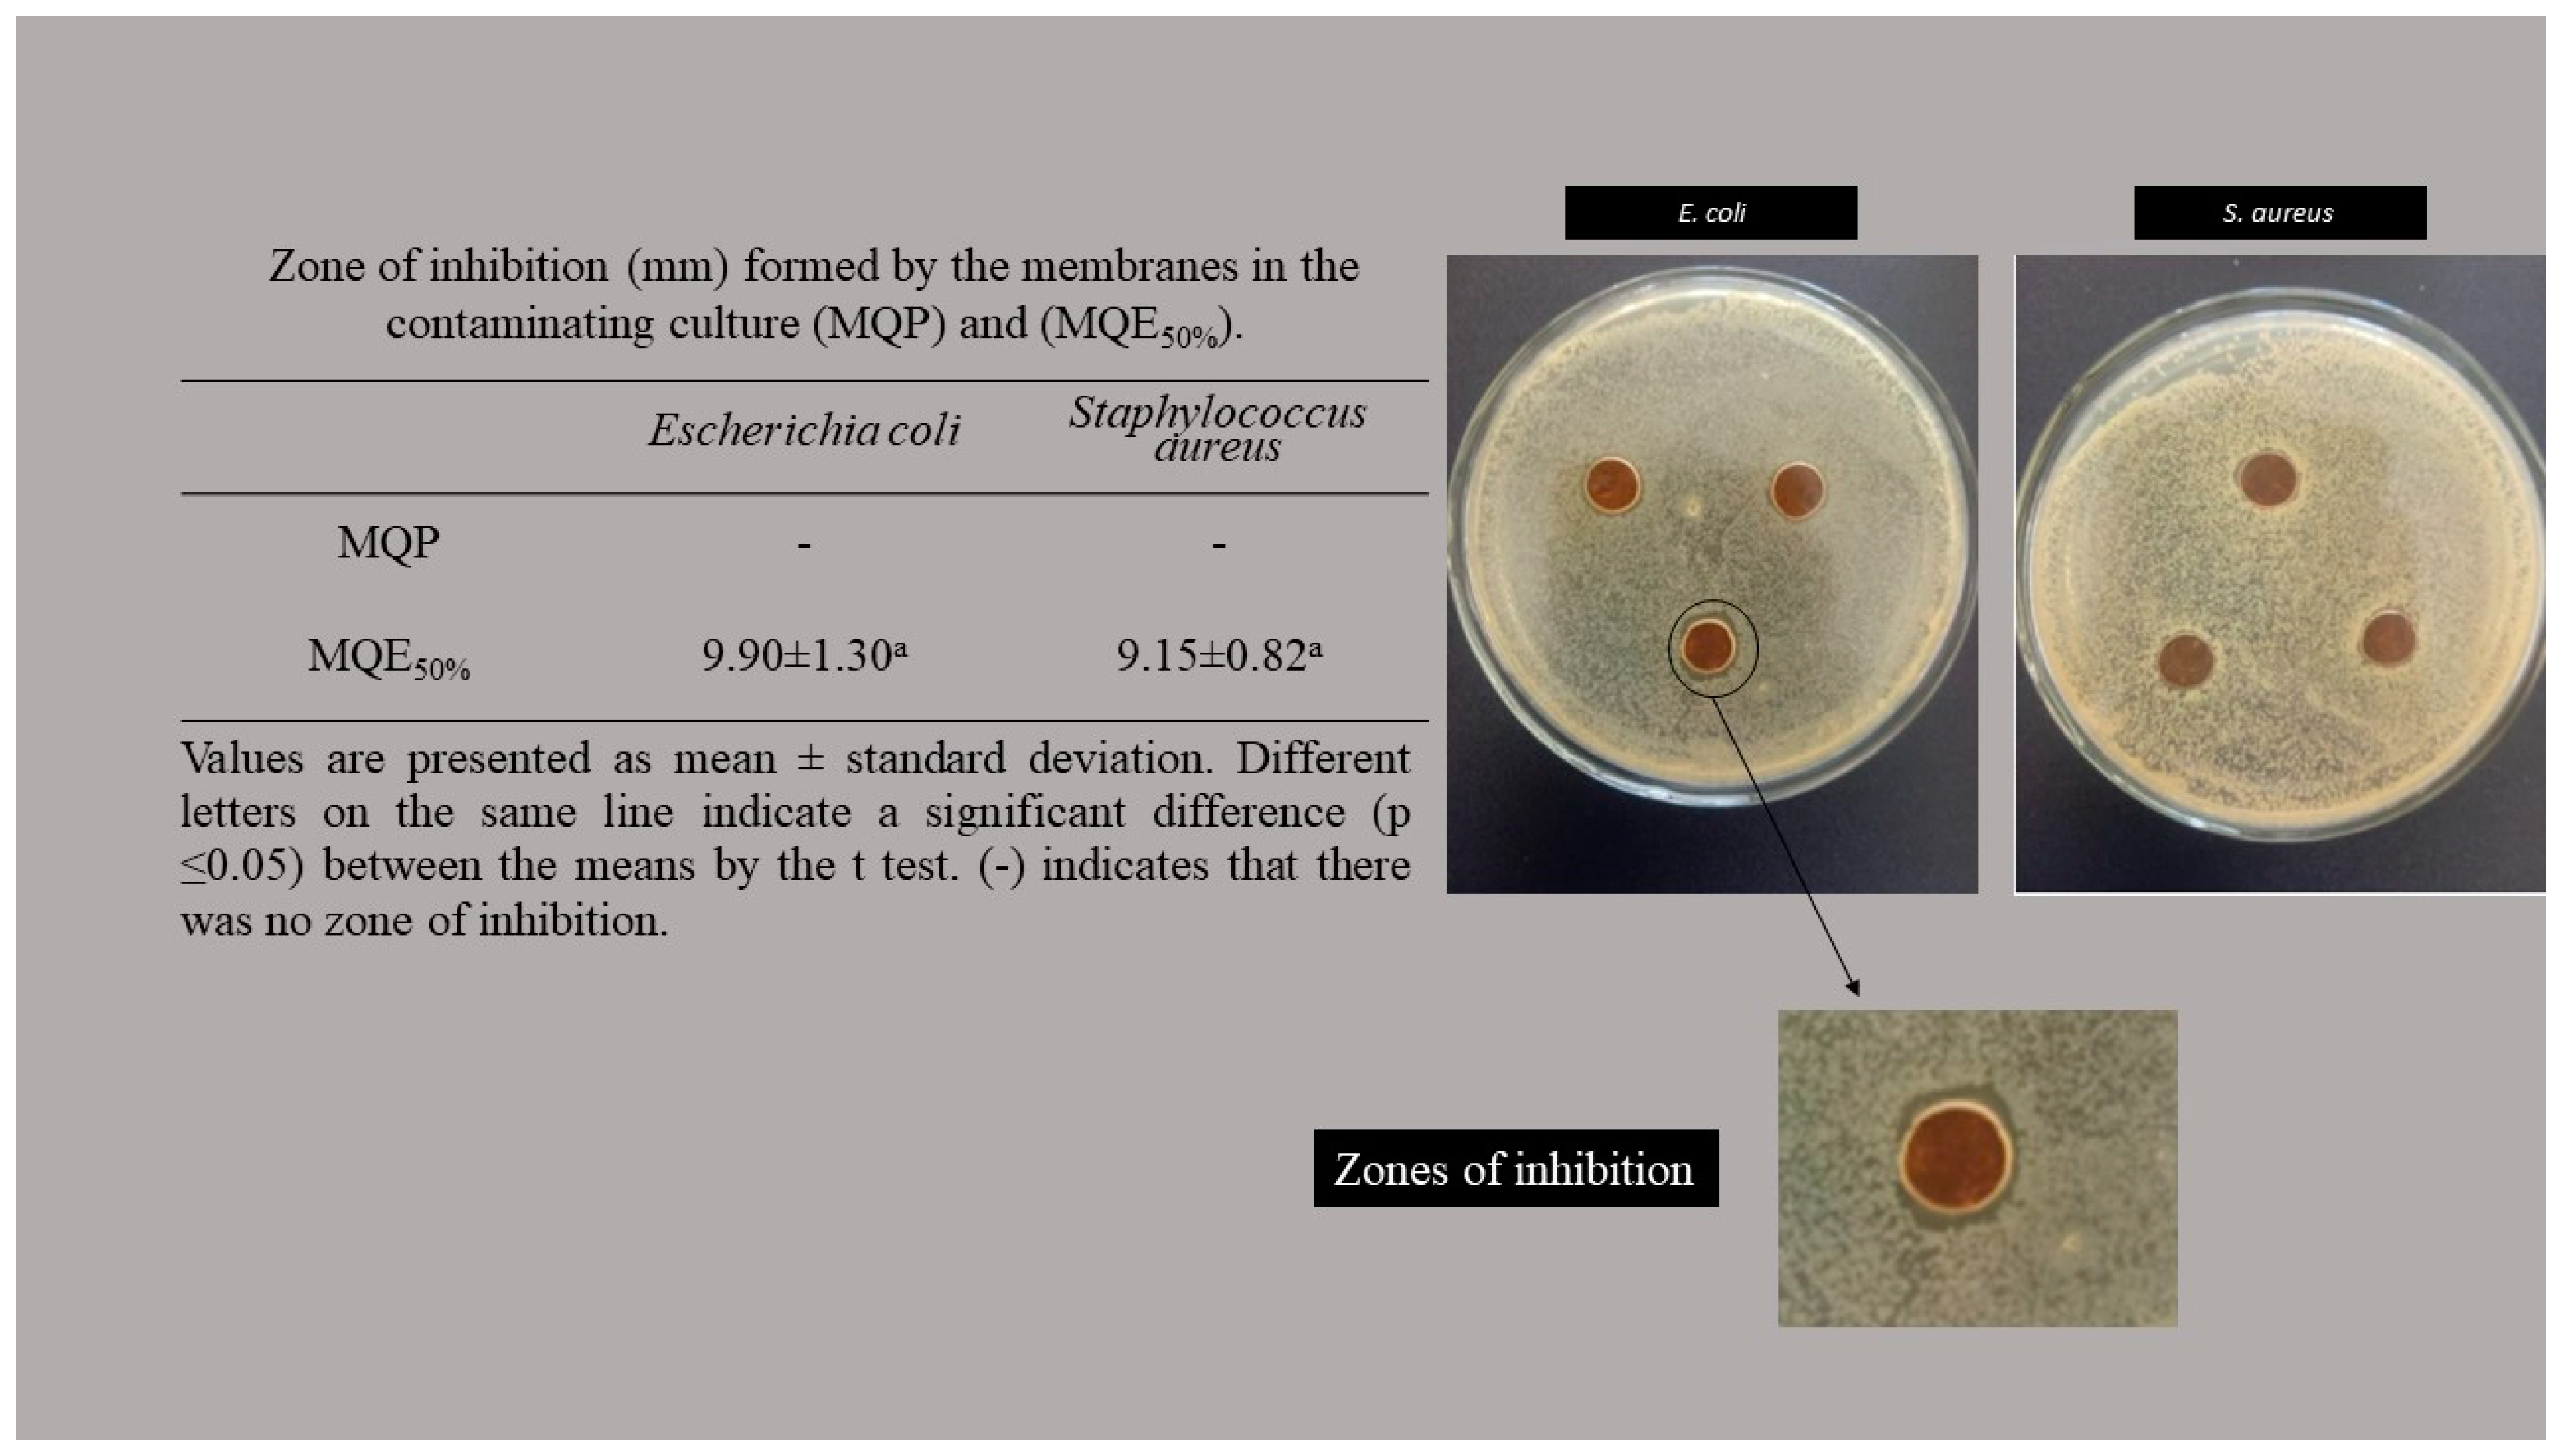
Macromol 03 00020 g003 Macromol 03 00020 g003

Biopolymeric Membranes with Active Principle of Olive Leaves (Olea europaea L.) for Potential Topical Application
Abstract
1. Introduction
2. Material and Methods
2.1. Material
2.2. Olive Leaf Extract (EFO)
2.3. Production of Membranes
2.4. Characterization of Membranes
2.4.1. Thickness
2.4.2. Mechanical Properties
2.4.3. Scanning Electron Microscopy
2.4.4. Water Vapor Permeability (WVP)
2.4.5. Solubility
2.4.6. Swelling
2.4.7. Fluid Drainage Capacity (FDC)
2.4.8. FTIR-ATR Analysis
2.4.9. Anti-Bacterial Property
2.4.10. Statistical Analysis
3. Results and Discussion
4. Conclusions
Author Contributions
Funding
Institutional Review Board Statement
Informed Consent Statement
Data Availability Statement
Conflicts of Interest
References
- Williams, P.L.; Bannister, L.H.; Berry, M.M.; Collins, P.; Dyson, M.; Dussek, J.E. Gray’s Anatomy—International Student Edition, 38th ed.; Churchill Livingstone: Oxford, UK, 1995. [Google Scholar]
- Agwa, M.M.; Sabra, S.; Atwa, N.A.; Dahdooh, H.Á.; Lithy, R.M.; Elmotasem, H. Potential of frankincense essential oil-loaded whey protein nanoparticles embedded in frankincense resin as a wound healing film based on green technology. J. Drug Deliv. Sci. Technol. 2022, 71, 103291. [Google Scholar] [CrossRef]
- Oliveira, J.G.F.; Lira, M.M.; Souza, T.L.; Campos, S.B.; Lemes, A.C.; Egea, M.B. Plant-based mucilage with healing and anti-inflammatory actions for topical application: A review. Food Hydrocoll. Health 2021, 1, 100012. [Google Scholar] [CrossRef]
- Liang, Y.; Liang, Y.; Zhang, H.; Guo, B. Antibacterial biomaterials for skin wound dressing. Asian J. Pharm. Sci. 2022, 24, 353–384. [Google Scholar] [CrossRef] [PubMed]
- Ousey, K. The role of topical metronidazole in the management of infected wounds. Wounds 2018, 14, 105–109. [Google Scholar]
- Abdel-Sayed, P.; Hirt-Burri, N.; Roessingh, A.B.; Raffoul, W.; Applegate, L.A. Evolution of Biological Bandages as First Cover for Burn Patients. Adv. Wound Care 2019, 8, 555–564. [Google Scholar] [CrossRef] [PubMed]
- Savencu, I.; Iurian, S.; Porfire, A.; Bogdan, C.; Tomuta, I. Review of advances in polymeric wound dressing films. React. Funct. Polym. 2021, 168, 105059. [Google Scholar] [CrossRef]
- Varaprasad, K.; Jayaramudu, T.; Kanikireddy, V.; Toro, C.; Sadiku, E.R. Alginate-based composite materials for wound dressing application: A mini review. Carbohydr. Polym. 2020, 236, 116025. [Google Scholar] [CrossRef]
- Moholkar, D.N.; Sadalage, P.S.; Peixoto, D.; Paiva-Santos, A.C.; Pawar, K.D. Recent advances in biopolymer-based formulations for wound healing applications. Eur. Polym. J. 2021, 160, 110784. [Google Scholar] [CrossRef]
- Jayakumar, R.; Prabaharan, M.; Kumar, P.T.S.; Nair, S.V.; Tamura, H. Biomaterials based on chitin and chitosan in wound dressing applications. Biotechnol. Adv. 2011, 29, 322–337. [Google Scholar] [CrossRef]
- Khan, Z.A.; Jamil, S.; Akhtar, A.; Mustehsan, B.; Yar, M. Chitosan based hybrid materials used for wound healing applications- A short review. Int. J. Polym. Mater. Polym. Biomater. 2020, 69, 419–436. [Google Scholar] [CrossRef]
- Oliveira, A.L.S.; Gondim, S.; Gómez-Garcia, R.; Ribeiro, T.; Pintado, M. Olive leaf phenolic extract from two Portuguese cultivars –bioactivities for potential food and cosmetic application. J. Environ. Chem. Eng. 2021, 9, 106175. [Google Scholar] [CrossRef]
- Rosa, G.S.; Martiny, T.R.; Dotto, G.L.; Vanga, S.K.; Parrine, D.; Gariepy, Y.; Lefsrud, M.; Raghavan, V. Eco-friendly extraction for the recovery of bioactive compounds from Brazilian olive leaves. Sustain. Mater. Technol. 2021, 28, e00276. [Google Scholar] [CrossRef]
- Difonzo, G.; Pasqualone, A.; Silletti, R.; Cosmai, L.; Summo, C.; Paradiso, V.M.; Caponio, F. Use of olive leaf extract to reduce lipid oxidation of baked snacks. Food Res. Int. 2018, 108, 48–56. [Google Scholar] [CrossRef]
- Jimenez-lopez, C.; Carpena, M.; Lourenço-Lopes, C.; Gallardo-Gomez, M.; Lorenzo, J.M.; Barba, F.J.; Prieto, M.A.; Simal-Gandara, J. Bioactive Compounds and Quality of Extra Virgin Olive Oil. Foods 2020, 9, 1014. [Google Scholar] [CrossRef]
- Rocchetti, G.; Callegari, M.L.; Senizza, A.; Giuberti, G.; Ruzzolini, J.; Romani, A.; Urciuoli, S.; Nediani, C.; Lucini, L. Oleuropein from olive leaf extracts and extra-virgin olive oil provides distinctive phenolic profiles and modulation of microbiota in the large intestine. Food Chem. 2022, 380, 132187. [Google Scholar] [CrossRef] [PubMed]
- Papoti, V.T.; Papageorgiou, M.; Dervisi, K.; Alexopoulos, E.; Apostolidis, K.; Petridis, D. Screening Olive Leaves from Unexploited Traditional Greek Cultivars for Their Phenolic Antioxidant Dynamic. Foods 2018, 7, 197. [Google Scholar] [CrossRef]
- Abi-Khattar, A.M.; Boussetta, N.; Rajha, H.N.; Abdel-Massih, R.M.; Louka, N.; Maroun, R.G.; Vorobiev, E.; Debs, E. Mechanical damage and thermal effect induced by ultrasonic treatment in olive leaf tissue. Impact on polyphenols recovery. Ultrason. Sonochem. 2022, 82, 105805. [Google Scholar] [CrossRef]
- Romani, A.; Ieri, F.; Urciuoli, S.; Noce, A.; Marrone, G.; Nediani, C.; Bernini, R. Health Effects of Phenolic Compounds Found in Extra-Virgin Olive Oil, By-Products, and Leaf of Olea europaea L. Nutrients 2019, 11, 1776. [Google Scholar] [CrossRef]
- Martiny, T.R.; Raghavan, V.; Moraes, C.C.; Rosa, G.S.; Dotto, G.L. Optimization of green extraction for the recovery of bioactive compounds from Brazilian olive crops and evaluation of its potential as a natural preservative. J. Environ. Chem. Eng. 2021, 9, 105130. [Google Scholar] [CrossRef]
- Rosa, G.S.; Vanga, S.K.; Gariepy, Y.; Raghavan, V. Development of biodegradable films with improved antioxidante properties based on the addition of carrageenan containing olive leaf extract for food packaging applications. J. Polym. Environ. 2019, 28, 123–130. [Google Scholar] [CrossRef]
- Contessa, C.R.; Rosa, G.S.; Moraes, C.C. New Active Packaging Based on Biopolymeric Mixture Added with Bacteriocin as Active Compound. Int. J. Mol. Sci. 2021, 22, 10628. [Google Scholar] [CrossRef]
- ASTM D882-18; Standard Test Method for Tensile Properties of Thin Plastic Sheeting. Annual Book of ASTM Standards. ASTM: Philadelphia, PA, USA, 2018.
- ASTM E96/E96M–16; Standard Test Methods for Water Vapor Transmission of Materials. Annual Book of ASTM Standards. ASTM: Philadelphia, PA, USA, 2016.
- Riaz, A.; Lei, S.; Akhtar, H.M.S.; Wan, P.; Chen, D.; Jabbar, S.; Abid, M.; Hashim, M.M.; Zeng, X. Preparation and characterization of chitosan-based antimicrobial active food packaging film incorporated with apple peel polyphenols. Int. J. Biol. Macromol. 2018, 114, 547–555. [Google Scholar] [CrossRef]
- BS EN 13726-1:2002; Test Methods for Primary Wound Dressings. Part 1: Aspects of Absorbency, Fluid Handling Capacity. British Standards Institute—BSI: London, UK, 2002.
- NCCLS. Performance Standards for Antimicrobial Disk Susceptibility Tests; Approved Standard. NCCLS Document M2-A8. Pennsylvania, USA. 2003. Available online: http://www.anvisa.gov.br/servicosaude/manuais/clsi/clsi_OPASM2-A8.pdf (accessed on 22 March 2023).
- Benavente-Garcia, O.; Castilho, J.; Lorente, J.; Ortuno, A.; Rio, J.A. Antioxidant activity of phenolics extracted from Olea europaea L. leaves. Food Chem. 2000, 68, 457–462. [Google Scholar] [CrossRef]
- Riaz, A.; Lagnika, C.; Luo, H.; Dai, Z.; Nie, M.; Hashim, M.M.; Liu, C.; Song, J.; Li, D. Chitosan-based biodegradable active food packaging film containing Chinese chive (Allium tuberosum) root extract for food application. Int. J. Biol. Macromol. 2020, 150, 595–604. [Google Scholar] [CrossRef]
- Contessa, C.R.; Souza, N.B.; Gonçalo, G.B.; Moura, C.M.; Rosa, G.S.; Moraes, C.C. Development of Active Packaging Based on Agar-Agar Incorporated with Bacteriocin of Lactobacillus sakei. Biomolecules 2021, 11, 1869. [Google Scholar] [CrossRef]
- Crizel, T.M.; Rios, A.O.; Alves, V.D.; Bandarra, N.; Moldão-Martins, M.; Flôres, S.H. Active food packaging prepared with chitosan and olive pomace. Food Hydrocoll. 2018, 74, 139–150. [Google Scholar] [CrossRef]
- Khaliq, T.; Sohail, M.; Minhas, M.U.; Shah, A.S.; Jabeen, N.; Khan, S.; Hussain, Z.; Mahmood, A.; Kousar, M.; Rashid, H. Self-crosslinked chitosan/κ-carrageenan-based biomimetic membranes to combat diabetic burn wound infections. Int. J. Biol. Macromol. 2022, 197, 157–168. [Google Scholar] [CrossRef] [PubMed]
- Wang, C.; Li, B.; Chen, T.; Mei, N.; Wang, X.; Tanq, S. Preparation and bioactivity of acetylated konjac glucomannan fibrous membrane and its application for wound dressing. Carbohydr. Polym. 2020, 229, 115404. [Google Scholar] [CrossRef] [PubMed]
- Annaidh, A.N.; Bruyere, K.; Destrade, M.; Gilchrist, M.; Otténio, M. Characterization of the anisotropic mechanical properties of excised human skin. J. Mech. Behav. Biomed. Mater. 2012, 5, 139–148. [Google Scholar] [CrossRef]
- Hassan, A.; Niazi, M.B.K.; Hussain, A.; Farrukh, S.; Ahmad, T. Development of Anti-bacterial PVA/Starch Based Hydrogel Membrane for Wound Dressing. J. Polym. Environ. 2018, 26, 235–243. [Google Scholar] [CrossRef]
- Jamróz, E.; Janik, M.; Juszczak, L.; Kruk, T.; Kulawik, P.; Szuwarzynski, M.; Kawecka, A.; Khachatryan, K. Composite biopolymer films based on a polyelectrolyte complex of furcellaran and chitosan. Carbohydr. Polym. 2021, 274, 118627. [Google Scholar] [CrossRef] [PubMed]
- Jamróz, E.; Tkaczewska, J.; Juszczak, L.; Zimoswska, M.; Kawecka, A.; Krzysciak, P.; Skora, M. The influence of lingonberry extract on the properties of novel, double-layered biopolymer films based on furcellaran, CMC and a gelatin hydrolysate. Food Hydrocoll. 2022, 124, 107334. [Google Scholar] [CrossRef]
- Genevro, G.M.; Gomes, N.R.J.; Paulo, L.A.; Lopes, P.S.; Moraes, M.A.; Beppu, M.M. Glucomannan asymmetric membranes for wound dressing. J. Mater. Res. 2019, 34, 481–489. [Google Scholar] [CrossRef]
- Zhang, T.; Xu, H.; Zhang, Y.; Zhang, Z.; Yang, X.; Wei, Y.; Huang, D.; Lian, X. Fabrication and characterization of double-layer asymmetric dressing through electrostatic spinning and 3D printing for skin wound repair. Mater. Des. 2022, 128, 110711. [Google Scholar] [CrossRef]
- Soares, L.S.; Perim, R.B.; Alvarenga, E.S.; Guimarães, L.M.; Teixeira, A.V.N.C.; Coimbra, J.S.R.; Oliveira, E.B. Insights on physicochemical aspects of chitosan dispersion in aqueous solutions of acetic, glycolic, propionic or lactic acid. Int. J. Biol. Macromol. 2019, 128, 140–148. [Google Scholar] [CrossRef]
- Alavi, T.; Rezvanian, M.; Ahmad, N.; Mohamad, N.; Shiow-Fern, N. Pluronic-F127 composite film loaded with erythromycin for wound application: Formulation, physicomechanical and in vitro evaluations. Drug Deliv. Transl. Res. 2019, 9, 508–519. [Google Scholar] [CrossRef] [PubMed]
- Razzaq, H.A.A.; Ayala, G.G.; Santagata, G.; Bosco, F.; Mollea, C.; Larsen, N.; Duraccio, D. Bioactive films based on barley β-glucans and ZnO for wound healing applications. Carbohydr. Polym. 2021, 272, 118442. [Google Scholar] [CrossRef]
- Narasagoudr, S.S.; Hegde, V.G.; Chougale, R.B.; Masti, S.P.; Dixit, S. Influence of boswellic acid on multifunctional properties of chitosan/poly (vinyl alcohol) films for active food packaging. Int. J. Biol. Macromol. 2020, 154, 48–61. [Google Scholar] [CrossRef]
- Pacheco, M.S.; Kano, G.E.; Paulo, L.A.; Lopes, P.S.; Moraes, M.A. Silk fibroin/chitosan/alginate multilayer membranes as a system for controlled drug release in wound healing. Int. J. Biol. Macromol. 2020, 152, 803–811. [Google Scholar] [CrossRef]
- Ma, Y.; Xin, L.; Tan, H.; Fan, M.; Li, J.; Jia, Y.; Ling, Z.; Chen, Y.; Hu, X. Chitosan membrane dressings toughened by glycerol to load antibacterial drugs for wound healing. Mater. Sci. Eng. C 2017, 81, 522–531. [Google Scholar] [CrossRef]
- Zhang, W.; Jiang, Q.; Shen, J.; Gao, P.; Yu, D.; Xu, Y.; Xia, W. The role of organic acid structures in changes of physicochemical and antioxidant properties of crosslinked chitosan films. Food Packag. Shelf Life 2022, 31, 100797. [Google Scholar] [CrossRef]
- Khalatbari, E.; Tajabadi, M.; Khavandi, A. Multifunctional exosome-loaded silk fibroin/alginate structure for potential wound dressing application. Mater. Commun. 2022, 31, 103549. [Google Scholar] [CrossRef]
- Yu, X.; Guo, L.; Cao, X.; Shang, S.; Liu, Z.; Huang, D.; Cao, Y.; Cui, F.; Tian, L. Callicarpa nudiflora loaded on chitosan-collagen/organomontmorillonite composite membrane for antibacterial activity of wound dressing. Int. J. Biol. Macromol. 2018, 120, 2279–2284. [Google Scholar] [CrossRef] [PubMed]
- Morgado, P.I.; Aguiar-Ricardo, A.; Correia, I.J. Asymmetric membranes as ideal wound dressings: An overview on production methods, structure, properties and performance relationship. J. Membr. Sci. 2015, 490, 139–151. [Google Scholar] [CrossRef]
- Psochia, E.; Papadopoulos, L.; Gkiliopoulos, D.J.; Francone, A.; Grigora, M.-E.; Tzetzis, D.; de Castro, J.V.; Neves, N.M.; Triantafyllidis, K.S.; Torres, C.M.S.; et al. Bottom-Up Development of Nanoimprinted PLLA Composite Films with Enhanced Antibacterial Properties for Smart Packaging Applications. Macromol 2021, 1, 49–63. [Google Scholar] [CrossRef]
- Azar, F.A.N.; Peseshki, A.; Ghanbarzadeh, B.; Hamishehkar, H.; Mohammadi, M.; Hamdipour, S.; Daliri, H. Pectin-sodium caseinat hydrogel containing olive leaf extract-nano lipid carrier: Preparation, characterization and rheological properties. LWT 2021, 148, 111757. [Google Scholar] [CrossRef]
- Avila, L.B.; Barreto, E.R.C.; Moraes, C.C.; Morais, M.M.; Rosa, G.S. Promising New Material for Food Packaging: An Active and Intelligent Carrageenan Film with Natural Jaboticaba Additive. Foods 2022, 6, 792. [Google Scholar] [CrossRef]
- Panda, P.K.; Yang, J.-M.; Chang, Y.-H.; Su, W.-W. Modification of different molecular weights of chitosan by p-Coumaric acid: Preparation, characterization and effect of molecular weight on its water solubility and antioxidant property. Int. J. Biol. Macromol. 2019, 136, 661–667. [Google Scholar] [CrossRef]
- Fang, W.; Yang, L.; Hong, L.; Hu, Q. A chitosan hydrogel sealant with self-contractile characteristic: From rapid and long-term hemorrhage control to wound closure and repair. Carbohydr. Polym. 2021, 271, 118428. [Google Scholar] [CrossRef]
- Sugumar, S.; Mukheejee, A.; Chandrasekaran, N. Eucalyptus oil nanoemulsion-impregnated chitosan film: Antibacterial effects against a clinical pathogen, Staphylococcus aureus, in vitro. Int. J. Nanomed. 2015, 10, 67–75. [Google Scholar] [CrossRef]
- Hafsa, J.; Smach, M.; Khedher, M.R.B.; Charfeddine, B.; Limem, K.; Majdoub, H.; Rouatbi, S. Physical, antioxidant and antimicrobial properties of chitosan films containing Eucalyptus globulus essential oil. LWT Food Sci. Technol. 2016, 68, 356–364. [Google Scholar] [CrossRef]
- Panda, P.K.; Sadegui, K.; Kitaee, P.; Seo, J. Regeneration Approach to Enhance the Antimicrobial and Antioxidant Activities of Chitosan for Biomedical Applications. Polymers 2023, 15, 132. [Google Scholar] [CrossRef] [PubMed]
- Rao, K.M.; Sudhakar, K.; Suneetha, M.; Won, S.Y.; Han, S.S. Fungal-derived carboxymethyl chitosan blended with polyvinyl alcohol as membranes for wound dressings. Int. J. Biol. Macromol. 2021, 190, 792–800. [Google Scholar] [CrossRef] [PubMed]
- Mayer, S.; Tallawi, M.; Luca, I.; Calarco, A.; Reinhardt, N.; Gray, L.A.; Drechsler, K.; Moeini, A.; Germann, N. Antimicrobial and physicochemical characterization of 2,3-dialdehyde cellulose-based wound dressings systems. Carbohydr. Polym. 2021, 272, 118506. [Google Scholar] [CrossRef]

| MQP | MQE50% | |
|---|---|---|
| TS (Mpa) | 72.41 ± 14.31 a | 30.17 ± 8.73 b |
| EB (%) | 41.69 ± 8.14 a | 38.64 ± 3.59 a |
| Thickness (mm) | 0.211 ± 0.023 b | 0.277 ± 0.027 a |
| WVP (kg·m−1·Pa−1·s−1) | 0.39 ± 0.1 a | 0.52 ± 0.22 a |
| Solubility (%) | 18.56 ± 1.64 b | 34.71 ± 2.62 a |
| Swelling (%) | 249.49 ± 4.77 a | 57.42 ± 1.13 b |
| FDC (g·m−2·h−1) | 22.75 ± 4.80 b | 29.31 ± 1.65 a |
Disclaimer/Publisher’s Note: The statements, opinions and data contained in all publications are solely those of the individual author(s) and contributor(s) and not of MDPI and/or the editor(s). MDPI and/or the editor(s) disclaim responsibility for any injury to people or property resulting from any ideas, methods, instructions or products referred to in the content. |
© 2023 by the authors. Licensee MDPI, Basel, Switzerland. This article is an open access article distributed under the terms and conditions of the Creative Commons Attribution (CC BY) license (https://creativecommons.org/licenses/by/4.0/).
Share and Cite
Alves, R.C.; Contessa, C.R.; Moraes, C.C.; Rosa, G.S.d. Biopolymeric Membranes with Active Principle of Olive Leaves (Olea europaea L.) for Potential Topical Application. Macromol 2023, 3, 314-325. https://doi.org/10.3390/macromol3020020
Alves RC, Contessa CR, Moraes CC, Rosa GSd. Biopolymeric Membranes with Active Principle of Olive Leaves (Olea europaea L.) for Potential Topical Application. Macromol. 2023; 3(2):314-325. https://doi.org/10.3390/macromol3020020
Chicago/Turabian StyleAlves, Rafael Carvalho, Camila Ramão Contessa, Caroline Costa Moraes, and Gabriela Silveira da Rosa. 2023. "Biopolymeric Membranes with Active Principle of Olive Leaves (Olea europaea L.) for Potential Topical Application" Macromol 3, no. 2: 314-325. https://doi.org/10.3390/macromol3020020
APA StyleAlves, R. C., Contessa, C. R., Moraes, C. C., & Rosa, G. S. d. (2023). Biopolymeric Membranes with Active Principle of Olive Leaves (Olea europaea L.) for Potential Topical Application. Macromol, 3(2), 314-325. https://doi.org/10.3390/macromol3020020

